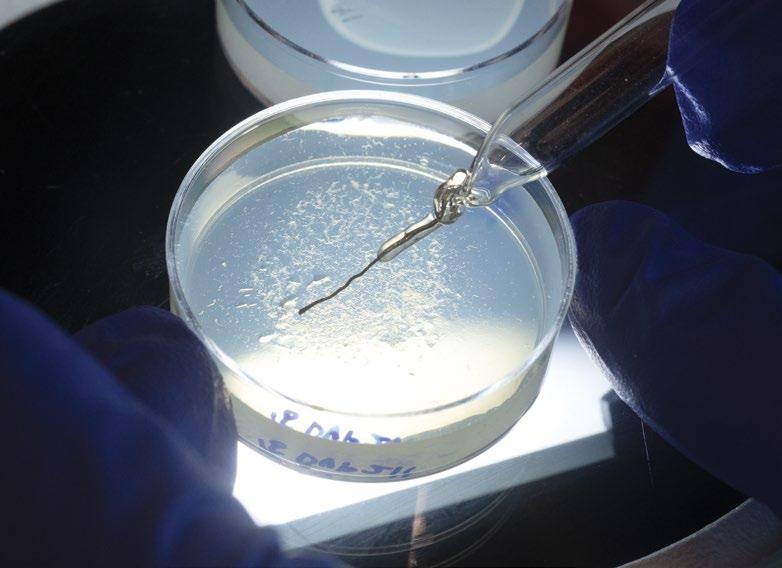

2022 SPECIAL ISSUE COBRE
Creating a Center of Biomedical Research Excellence


Neuroscience
The
award recognizes early-career scientists who are
exceptional neuroscience research… and
academic potential in their scientific training.”
partner in her journey of discovery. 4 CELEBRATING FEDERAL COBRE GRANTS Investments in Success for Early-Career Scientists and the MDI Biological Laboratory 14 THE NEXT PHASE MDIBL Seeks COBRE Support for Advanced Technology and Staff 16 THIS IS WHY: Inspiring Philanthropy: Laying the Groundwork for Lifesaving Breakthroughs 2022 SPECIAL ISSUE COBRE
Launchpad for Young Innovators ‹ LEARN MORE Learn more about Dr. Spaulding; scan this code with your smart phone camera.
MDIBL post-doctoral fellow Emily Spaulding, Ph.D., received a new kind of recognition from the National Institutes of Health this year: the Outstanding Scholars in
Award Program.
OSNAP
“conducting
have great
MDIBL is proud to be a
A
Dear Friends,
We are pleased to share this special issue of Breaking Through in recognition of all that the Centers of Biomedical Research Excellence (COBRE) federal research program has made possible at the MDI Biological Laboratory over the last decade.
The following pages highlight the many ways the COBRE program has helped MDIBL evolve from a largely seasonal operation into an international hub of research on aging, regeneration and tissue repair.


Administered by the National Institute of General Medical Sciences, since 2013 the COBRE grants helped bring nine outstanding young faculty on board, six of whom have gone on to win their first independent research grants.
We also secured state-of-the-art microscopy, bioinformatics services and significantly expanded the Laboratory’s cohort of transgenic animal models to support our faculty and visiting scientists. In short, the COBRE program has been a driving force in MDIBL’s growth, placing us on a new trajectory — a scientific journey into the mysteries of aging and regeneration
And we cannot overstate the importance of philanthropy in setting the stage for this transformation. Visionary donors such as Kathryn W. Davis and Wistar and Martha Morris imagined a future for the Laboratory that few others could, and they invested in it. We are inspired by their belief in us and their unwavering commitment to creating a world where each of us can live longer, healthier lives.
We are also thankful to Kevin Strange, Ph.D., for establishing a clear research vision for the COBRE and setting MDIBL on a course for success.
We could not be prouder of all that this program has allowed us to accomplish and for the vibrant scientific community it has fostered. And we could not be more grateful to each of you for your continued support and commitment to our future success.
With appreciation,
 Haller, M.D. President
Iain A. Drummond, Ph.D. Scientific Director
FROM OUR LEADERSHIP
Hermann
Haller, M.D. President
Iain A. Drummond, Ph.D. Scientific Director
FROM OUR LEADERSHIP
Hermann
BREAKING THROUGH SPECIAL ISSUE: COBRE 2022 › 3




AT LEFT, clockwise from top left:
Visiting Scientist Brett Keiper, Ph.D. and MDIBL Associate Professor Dustin Updike, Ph.D.; C.elegans roundworms; research assistants in the Kathryn W. Davis Center; axolotl salamanders
CELEBRATING FEDERAL COBRE SUPPORT
Investments in Success for Early-Career Scientists and the MDI Biological Laboratory

Dustin Updike, Ph.D., and his research group at the MDI Biological Laboratory are uncovering new truths about germ cells — the egg and sperm cells that are uniquely able to divide and differentiate into all other cell types.
The scientists are focusing on tiny, transparent C. elegans roundworms to illuminate some mysterious structures that are found inside their germ cells. Made of RNA and protein, the blob-like formations are called germ granules.

One early discovery at the Updike lab: how granules defend germ cells’ prolific capabilities — their “totipotency.”
Certain proteins in the granules, they found, prevent the germ cells from changing into specific cell types and losing their capacity for self-renewal. That stabilizes the organism’s fertility and supports genetic processes needed to regenerate damaged tissues.
“We see these granules and processes in roundworms, but the same things are happening in all animals, including humans,” Updike says. “That’s giving us insights into how fertility and cellular regeneration can be encouraged… or discouraged.”
Updike says it was support from the federal “Centers of Biomedical Research Excellence” program — COBRE for short — that propelled his work into new frontiers of basic cell science.
“It doubled the size of my staff,” he says. “It supported my lab and the institute’s infrastructure. It allowed me to get that work done.”
BREAKING THROUGH SPECIAL ISSUE: COBRE 2022 › 5
2022 SPECIAL ISSUE COBRE
NIH seeds growth
COBRE (pronounced COE-bree) is part of a National Institute of General Medical Sciences program, called the Institutional Development Award (IDeA), that funds biomedical science and education in geographic regions outside the more established research centers. Over the course of three decades, it’s cultivated the work of institutions and early-to-mid-career scientists in 23 states and Puerto Rico.
In 2013, here on rural Mount Desert Island, Updike joined three other scientists in the Laboratory’s new Kathryn W. Davis Center for Regenerative Biology and Aging to pursue — and win — what would become the center’s first COBRE award: a $13 million grant.
Updike says that as an early-career scientist, the influx of support allowed him to build a solid base of staff, equipment, research and publication. And it laid the groundwork for subsequent efforts to win more traditional funding.
“In these IDeA states like Maine, the program incentivizes research institutions and colleges and universities to hire new faculty,” Updike says. “And the expectation is they’ll be good enough and have enough resources to grow and then apply for independent funding.”
It worked for Updike. With help from COBRE-backed coaches and mentors, (including experts in writing grant applications) he won a coveted federal R01 grant within two years.
“And because of that I was booted off of the COBRE program,” he jokes. “‘Graduated’ is the nicer term — and that allowed us to recruit someone else under the same COBRE grant.”
Building a foundation for the future
Over time COBRE funding has provided $23 million to support innovative work by nine principal investigators at the Laboratory and built a platform for MDIBL’s emergence as an international hub for research on aging, regeneration and tissue repair.

“COBRE established a critical mass of research scientists at MDIBL,” says
Iain Drummond, Ph.D., the Davis Center’s director and the Principal Investigator for the grant. “It’s funded nine of our 11 labs — all top-notch, all internationally competitive. The foundation provided by COBRE will serve as a springboard for the maturation of the Laboratory.”
And it’s led to six other major National Institutes of Health grants, such as Updike’s R01 award, totaling more than $9 million. COBRE has also worked in partnership with private donors to the Laboratory: science-funding stalwarts such as Kathryn Davis and Wistar and Martha Morris, who have provided gifts of more than $10 million over the last decade. (See This is Why, page 14)
FAST FACTS: MDIBL In 2021 the pandemic forced some of MDIBL’s on-campus activities online, but the research and education mission continued to thrive. 11 faculty 12 additional staff 20 administrative support 35 research support operating budget of $15M (2022) 68 average total staff TEAM 6 ‹ BREAKING THROUGH SPECIAL ISSUE: COBRE 2022
SANDRA RIEGER, PH.D. COBRE RESEARCH PROJECT LEADER, 2013–2018
“COBRE established a critical mass of research scientists at MDIBL. It’s funded nine of our 11 labs — all top-notch, all internationally competitive.”
DRUMMOND, PH.D. PRINCIPAL INVESTIGATOR, PROFESSOR AND DIRECTOR, THE KATHRYN W. DAVIS CENTER FOR REGENERATIVE BIOLOGY AND AGING, MDIBL
IAIN
AWARDS
&
‹ LEARN MORE
View remarkable animations of microscopic models; scan this code with your smart phone camera.

ABOVE, left to right: Post-doctoral Researcher Aissette Baanannou, Ph.D., and Light Microscopy Facility Manager Frédéric Bonnet, Ph.D.; C.elegans
GRANTS
Maine
2.4K
Maine students trained in programs supported by federal grants (since 2001)


Working with transgenic zebrafish raised at the lab, Rieger demonstrated that inhibiting specific proteins can prevent or even reverse peripheral neuropathy — pain, tingling or temperature sensitivity — when it’s caused by certain chemotherapy treatments.
“I really established everything from scratch, and the early COBRE funds helped me to produce the preliminary data that started the entire project. The program also connected us with a network of institutions andscientists,whichwashelpful in getting the project going.”
Now at the University of Miami, Rieger has co-founded a company, Avantyx, that aims to cure chemotherapy-induced and diabetic peripheral neuropathy.
nearly
in federal grants (since 2001)
COBRE SPOTLIGHT
$2.4M distributed to subawards in
$200M
BREAKING THROUGH SPECIAL ISSUE: COBRE 2022 › 7
INBRE
The MDI Biological Laboratory’s successful evolution in the early 21stcentury was advanced considerably by the federal COBRE grants celebrated in this issue of BreakingThrough
That has gone hand-in-glove with a related federal program that put MDIBL at the center of a statewide network of 14 research and educational institutions that works to support and expand local opportunities for well-paid careers in biomedical science.
The collaboration is called the Maine IDeA Network of Biomedical Research Excellence (INBRE). Funded by NIGMS since 2001, the program takes advantage of faculty, research infrastructure and convening facilities throughout the state.
“In these IDeA states like Maine, the program incentivizes research institutions, colleges and universities to hire new faculty that can provide students with authentic research experiences
And the expectation is (the faculty) will… have enough resources to grow and then apply for independent funding.”
DUSTIN UPDIKE, PH.D. ASSOCIATE PROFESSOR
Univ. of Maine Fort Kent
Univ. of Maine Presque Isle
MAINE INBRE NETWORK
Colby College
Univ. of Maine Farmington
Bates College
Bowdoin College
Univ. of Maine
Univ. of Maine Honors College
Southern Maine Community College
Univ. of New England
Univ. of Maine Machias
College of the Atlantic
The Jackson Laboratory
research & educational institutions participate in the Maine INBRE network
Maine INBRE has been funded by NIGMS since
142001
Provides research support to help young biomedical science faculty compete for federal grants.
Modernizes scientific infrastructure through investments in shared, state-ofthe-art equipment.
Trains students in the technical skills needed for biomedical R&D.
A CLOSER LOOK:
8 ‹ BREAKING THROUGH SPECIAL ISSUE: COBRE 2022
Now, a final phase of the Laboratory’s COBRE journey will focus on enhancing its scientific and technical resources, such as bioinformatics, cloud computing, microscopy, and an expanded roster of animal models. (See The Next Phase, page 11)
Meantime, there are still three earlycareer scientists on campus whose investigations and advancement are directly supported by the earlier phases of the Laboratory’s COBRE grants. Jarod Rollins, Ph.D., is researching how lifespan-extending interventions such as dietary restriction regulate gene expression, protecting cells and tissues from age-related decline. COBRE funding, he says, is like an aerialist’s safety net.
“With money comes security, which provides the freedom to take risks, and that’s what you have to do if you want to make big discoveries and have a big impact,” Rollins says. “The COBRE funding has allowed our team to endure the failures. And, let’s be honest, failures are necessary to be truly innovative.”
Collaboration and convening
COBRE’s wide scope has also fostered a culture of collaboration across disciplines at the Laboratory, sparking new scientific insights and creating real excitement among the researchers.
“It’s a kind of cross-fertilization that wouldn’t exist anywhere else,” says James Godwin, Ph.D. He studies the role scarring plays in inhibiting regeneration in humans and how animals such as axolotl salamanders can regenerate tissues, organs and limbs. But he also works closely with scientists at the Laboratory whose focus is on aging.
‹ LEARN MORE
Learn more about our research faculty; scan this code with your smart phone camera.
 JAROD ROLLINS, PH.D. ASSISTANT PROFESSOR
JAROD ROLLINS, PH.D. ASSISTANT PROFESSOR
In 2019, he, Rollins and Sam Beck, Ph.D. — another COBRE recipient — organized the 2019 RegenAge symposium. It was a first-of-its kind event on the interface between these fields and one of several COBREsupported symposia that have brought the world to the Laboratory’s doorstep.
“The ability to regenerate is linked to age, but these fields are usually quite disconnected,” Godwin says. “So the opportunity to collaborate and share ideas with colleagues at MDIBL who are thinking about aging and longevity is a dream.”

Unlocking mysteries and advancing careers
Central to the scientific enterprise, COBRE is helping MDIBL and its scientists penetrate some of nature’s closely-held secrets.
Back in 2013, a paper in the journal Cell identified nine “hallmarks of aging,” such as the degradation of gene structures and expression, cellular senescence, and a decline in stem cell persistence.
VICKI
LOSICK, PH.D.
COBRE RESEARCH PROJECT LEADER, 2015–2017
Losick’s early work at MDIBL brought new insights into the role that polyploidization, or cell enlargement, plays in wound repair. It took her just a year to advance from the foundation provided by the Laboratory’s COBRE grant to winning recognition and new funding from the National Institute of General Medical Sciences with an “Outstanding Investigator” award.
“COBRE provided the mentorship infrastructure for junior PIs with a team of experts to evaluate their science and offer constructivefeedback.Receiving grant-writing assistance earlier on from an outside advisor in yourfieldwasahugeadvantage.”
Now at Boston College, Losick’s lab is identifying methodologies to support tissue repair by encouraging beneficial polyploidization or reducing its potentially harmful consequences.
SPOTLIGHT
COBRE
“With money comes security, which provides the freedom to take risks, and that’s what you have to do if you want to make big discoveries and have a big impact. The COBRE funding has allowed our team to endure the failures. And, let’s be honest, failures are necessary to be truly innovative.”
9
COBRE SPOTLIGHT
The “geroscience hypothesis” holds that since aging plays a role in disorders such as Alzheimer’s, cancer, diabetes and heart disease, slowing the rate of aging should slow their onset.
JAMES A. COFFMAN, PH.D.
COBRE RESEARCH PROJECT LEADER, 2013–2017
INBRE PRINCIPAL INVESTIGATOR, 2016–2022
Coffman spent his early career researching genetic processes in sea urchin embryos and environmental factors affecting gene expression. But he switched gears mid-career, helped along by the COBRE grant’s provisions for scientists who want to jump into new lines of inquiry.

Turning to zebrafish models, Coffman’s subsequent work has focused on the gene-level role that chronic stress plays in lifetime and multi-generational susceptibility to disease.
“The COBRE opportunity reignited my passion for science. I’mstillworkingonfundamentals of gene regulation, but now I can relate it to the big picture, which is a looming public health crisis that’s driven by the stressfulness of life in the 21st century.”
The concept has stimulated development of some promising anti-aging drug candidates, but biological commonalities that may underpin the hallmarks of aging have remained a mystery… until now. Recent work at the Laboratory proposes a unified theory that links the hallmarks.
Beck’s been researching HutchinsonGuilford progeria syndrome, a rare genetic condition that accelerates aging in children. With COBRE support, Beck made a deep computational dive into large-scale, publicly available genomic data related to the disease, and then validated his analysis with mouse models.
He found that disrupting the architecture of a part of the cell’s nucleus that carries genetic information, the chromatin, leads to a loss of the functional identity of aging cells and ultimately to agerelated degenerative disease. This means that, for instance, pancreatic cells partly lose their function as pancreatic cells.
The finding opens a door to the development of drugs that prolong healthy lifespan by protecting, or even restoring, aging chromatin architecture.
“COBRE gave me the opportunity to come here and establish the research program,” Beck says.
And the work helped him win an R01 grant last summer, making Beck the Laboratory’s latest COBRE “graduate.” That funding will support the next stage of his career, at Boston University. Beck says he’ll still work closely, though, with MDIBL colleagues such as Godwin.
In 2021, Beck and Godwin co-published research linking chromatin disruption and the misexpression of a specific set of genes, revealing new areas for inquiry into how to slow aging at the cellular level.
“Dr. Godwin is a top-notch investigator with a deep understanding of inflammation and genetics,” Beck says. “We hope our interdisciplinary research can yield new insights into the pathophysiology of aging, as well as effective therapeutic strategies against aging and age-related diseases.”
By assembling outstanding research teams and promoting creative collaborations, COBRE has launched the Laboratory and its scientists on a growth trajectory, creating new opportunities and elevating their respective roles on the global stage.
“Most, if not all, of the scientific output generated by the MDIBL over the last decade has been touched either directly or indirectly by COBRE support,” says Alejandro Sánchez Alvarado, Ph.D. He’s Chief Scientific Officer of the Stowers Institute for Medical Research and a founding member of the board of outside advisors for the MDI Biological Laboratory’s COBRE grants.
“To say that COBRE transformed research activities at the MDIBL would be an understatement.”
FAST FACTS: ANIMALS
Finding the best animal models is essential to MDIBL’s comparative research. Our scientists study a wide array of model organisms in search of deeper insights into the mechanisms of disease, aging, and healing.
1,404 three liter tanks 10–15 fish per tank 4 species African turquoise killifish, axolotl, C. elegans and zebrafish up to 17,025 total fish population ZEBRAFISH 10 ‹ BREAKING THROUGH SPECIAL ISSUE: COBRE 2022
Marko Pende,
image of an axolotl won recognition in Nikon’s “Small World Photomicrography” Competition; the salamander’s nervous system is illuminated — Schwann cells in cyan, and axons in magenta.

THE NEXT PHASE
MDIBL Seeks COBRE
Since the late 19th-century the MDI Biological Laboratory has been a summertime incubator of scientific excellence. Starting in the early 2000s, a series of federal grants encouraged a new cohort of innovators to bring their research here year-round.
them,” says Prayag Murawala, Ph.D. “Now as the days are passing, new technologies are evolving. And these technologies enable us to answer these questions.”
Support
for Advanced Technology and Staff
Now the Laboratory is pursuing a final allotment from one of those grants, to put its technological capabilities on a new level as well. The investment of more than $3 million in technical staff and infrastructure would add to MDIBL’s growing stature as a world-class resource for the study of aging, regeneration, and the repair of living tissues.
“One hundred years ago, scientists were asking the same questions, but they did not have the tools or the means to address
Murawala is one of the early-career scientists whose research group was established with funding by the “Centers of Biomedical Research Excellence (COBRE)” grant program, administered by the National Institute of General Medical Sciences.
He’s a specialist in comparative biology and the axolotl salamander, which has astounding abilities to regenerate limbs, tissue and even its brain.
“The central question I and many colleagues across the world are focusing on is: how can these animals regenerate?” Murawala says. “And why can’t we do that?”
390 three liter tanks 2 fish per tank approximately 2K axolotl adults approximately 4.5K total axolotl population up to 82 total fish population AXOLOTL AFRICANTURQUOISEKILLIFISH
BREAKING THROUGH SPECIAL ISSUE: COBRE 2022 › 11
Ph.D.’s
AT LEFT, top to bottom: Post-doctoral researcher Marko Pende, Ph.D., examines an axolotl salamander; “Merging Traffic” by Hannah Somers. C.elegans nematode with muscles in yellow and ribosomes in purple.


The Laboratory is seeking additional COBRE support for its animal husbandry core as it develops a wider array of transgenic model animals such as axolotl, zebrafish and African turquoise killifish. For MDIBL’s investigators, the animals are windows on cellular and molecular processes that point to new treatments for human injury, disease, and agerelated decline.
“We have been one of the leaders in developing these transgenic animals and we want to keep on that track,” Murawala says.
To open the research window even wider, the grant would enhance the Laboratory’s bioinformatics capacity and facilitate plans to build a half-million-dollar, stateof-the-art light sheet microscope.
The cutting-edge system provides unprecedented clarity and speed in the three-dimensional depiction of subjects ranging in size from the cellular to the molecular. It allows entire organs and organisms to be imaged, with the ability to close in on their anatomy at the cellular level — and from any angle.
“For those purposes it’s a far superior technology compared to other microscopy,” Murawala says.
Recently pioneered in the Helmchen lab at the University of Zurich, it’s called “mesoSPIM,” for meso-scale selective plane illumination microscopy. MDIBL’s version will be one of only four like it in the U.S., and it will be available to a wide array of researchers in and outside of Maine.
C. ELEGANS approximately 2K germ cells 959 somatic cells per adult animal Roughly 21K genes most of them conserved in both C. elegans and humans Up to a 30 day lifespan 1 mm long 1 µm thick 12
IAIN DRUMMOND, PH.D. PRINCIPAL INVESTIGATOR, PROFESSOR AND DIRECTOR, THE KATHRYN W. DAVIS CENTER FOR REGENERATIVE BIOLOGY AND AGING,
With advice from one of the Zurich experts, Murawala is assembling the laserbased microscope alongside Marko Pende, Ph.D., a post-doctoral bioengineer in his lab. Pende studies how limb regeneration is regulated in axolotls, but he’s also an expert science imager who’s inventing new ways to “clear” tissue samples, making them transparent for easier viewing.
“What is the 3D architecture of the nervous system? What is the 3D architecture of a blood vessel?” Murawala asks. “These are questions that can only be answered if you do in toto imaging of your sample. Combined with our strength in tissue-clearing, mesoSPIM will be a game changer.”
And it’s a technological advance that the Laboratory will share with scientists and students around the state of Maine and beyond.
Frédéric Bonnet, Ph.D., who manages the MDIBL Light Microscopy Facility, says the system will be available to the entire network of 14 Maine education and research institutions that access the Laboratory’s infrastructure thanks to a linked federal program called the IDeA Network of Biological Research Excellence,
MDIBL
or INBRE (see page 8), for research and education.
180 facilities in the BioImaging North America network (BINA) will also gain access.
“Our overall goal is that the microscope will be open to everyone who wants to try it and to run a project,” Bonnet says. “We will establish a nationwide imaging service focused on tissue clearing and mesoSPIM imaging.”
And, he notes, the MDIBL’s dorms and cottages for visiting students and scientists can host researchers seeking significant time with the microscope. That would be another important element of the latest phase of the federal grant: funding for pilot projects proposed by outside researchers.
“We want people to come here and contribute, innovate and thrive,” says Iain Drummond, Ph.D., Principal Investigator for the MDIBL’s COBRE awards. “We want young people to go on and seed the rest of the country with groundbreaking discoveries, systems of discovery. It’s ongoing — generating the next generations’ innovators.”
ALEXANDRA CEURVORST FACILITIES MANAGER, ANIMAL RESOURCES CORE

Ceurvorst cares for thousands of model fish, salamanders and roundworms (and more) in the Laboratory’s animal husbandry operations. In the next phase of COBRE funding support for personnel on her team, the Core would expand the number of transgenic lines propagated at the Laboratory.
“COBRE has provided support for animal technicians and colony managers who attend our Health and Colony Management of Laboratory Fish course. That’s the kind of opportunity that drives improvements in animal welfare, biosecurity and researchreproducibility.Andthe courses and conferences also foster collaboration and relationships with other institutions, investigators and vendors.”
“We want young people to go on and seed the rest of the country with groundbreaking discoveries, systems of discovery. It’s ongoing — generating the next generations’ innovators.”
MICROSCOPY 7 microscopes 187
user hours
COBRE SPOTLIGHT
external
(2022)
1 remote service program 257% increase in INBRE network user hours (2019 to 2022) 294% increase in internal user hours (2019 to 2022) 3,268 MDIBL user hours (2022) BREAKING THROUGH SPECIAL ISSUE: COBRE 2022 › 13
Generous support from far-sighted philanthropists
Martha Morris (l.), Kathryn Davis and Wistar Morris were essential to MDIBL’s transformation over the last decade.
Inspiring Philanthropy
Laying the groundwork for lifesaving breakthroughs
Federal grants such as the IDeA program play an essential role in supporting the MDI Biological Laboratory’s research and education programs, but private philanthropy is a crucial partner in making outstanding science possible.
Philanthropy can be the catalyst that allows a scientist to obtain his or her first research grant. This is why charitable support from donors like you is so important. Your generosity provides the vital seed money needed to establish proof-of-concept for a scientific enterprise and generate the data that convinces federal funders of its worth.
We appreciate each and every one of our donors who generously support the Laboratory’s innovative research and
educational programs. We could not do this work without you.
We are profoundly grateful to Kathryn W. Davis and Wistar and Martha Morris for their partnership in shaping the MDI Biological Laboratory into an international hub for the growing field of regenerative and aging biology. Their belief and trust in us, their ability to see the possibilities when few others could, inspired us to believe in ourselves.
The Morris and Davis buildings proved to be a transformative space for our year-round faculty and a force-multiplier for our work. The high-tech facilities are key to the recruitment and retention of the most talented researchers for MDIBL’s Center of Biomedical Research
Excellence and to accelerating additional federal funding.
The visionary philanthropy of the Davis and Morris families laid the groundwork for lifesaving research breakthroughs and positioned the MDI Biological Laboratory to play a pivotal role in extending healthy lifespans.


‹ SUPPORT MDIBL
Learn how to support MDIBL; scan this code with your smart phone camera.

14 ‹ BREAKING THROUGH SPECIAL ISSUE: COBRE 2022
We aim to improve human health by discovering novel mechanisms of tissue repair, aging and regeneration, translating our discoveries for the benefit of medicine and society and developing the next generation of scientific leaders.
BOARD OF TRUSTEES
Alan W. Kornberg, Esq., Chairman
Paul, Weiss, Rifkind, Wharton & Garrison LLP
Edward J. Benz Jr., M.D., Vice Chairman
Dana Farber Cancer Institute
Thomas A. Boyd, Ph.D., Treasurer
Anthology BioDevelopment LLC
Janis L. Coates, Ph.D., Secretary
Island Readers and Writers
Hermann Haller, M.D., ex officio
MDI Biological Laboratory, President
James L. Boyer, M.D., Honorary Trustee
Yale University
Phoebe C. Boyer
Children’s Aid
Terence C. Boylan
The River Press
Ruth Cserr
Sigmar H. Gabriel
John A. Hays Christie’s
Anne H. Lehmann
Anna Maynard
Alan B. Miller, Esq.
I. Wistar Morris III
Margaret Myers, M.D.
Dennis L. Shubert, M.D., Ph.D. Christopher P. Sighinolfi
Bruce A. Stanton, Ph.D.
Geisel School of Medicine at Dartmouth
Clare Stone
Daphne W. Trotter, Esq. McDermott Will & Emery LLP
Robert Taft Whitman
Published by the Office of Development and Public Affairs
Editors + Writers Stefanie Matteson, Anna Farrell, Jeri Bowers, Fred Bever
Design Cushman Creative
Photography Kevin Bennett, Rogier van Bakel, Anna Farrell, Marko Pende, Ph.D., Hannah Somers, Mike York
MDI Biological Laboratory
PO Box 35, Salisbury Cove, ME 04672
Website: mdibl.org
Email: breakingthrough@mdibl.org
PHILANTHROPY
SPOTLIGHT
Changing the Way
We See the World
Remember that microscope you used in high school biology class? Today, technology is taking microscopy to entirely new places. These computer driven microscopes are pushing the boundaries of science by allowing scientists to visualize and measure greater levels of detail than ever before. And they are changing our understanding of how cells communicate with one another and respond to injury or disease.
Thanks to you, scientists at the MDI Biological Laboratory are at the forefront of this field.
Your generous support is allowing scientists like Marko Pende, Ph.D., to develop sophisticated new tools that will advance our ability to see deep into tissues and cells and to observe cellular processes in 3D.

Philanthropic support from donors like you fosters creativity and innovation — and helps change the way we see the world. It provides Marko and his colleagues with the freedom to explore new ideas, discover new knowledge and ultimately improve human health.
Please make your gift to our 2022 Annual Fund today to ensure they can continue their important work. Visit mdibl.org/donate-now to learn more.
ABOUT US



MDIBL? Do Tell! Help us to reflect on the past and inspire our future. NEXT SUMMER marks the Laboratory’s
year as an
haven for scientists and their inquiries. As we begin to celebrate this historic milestone together we want to hear from you! Please share your memories, stories and anecdotes at mdibl.org/memories MDI Biological Laboratory PO Box 35 Salisbury Cove, ME 04672 mdibl.org Subscribe to our e-newsletter or update your preferences at mdibl.org/subscribe Connect with us
125th
island









 Haller, M.D. President
Iain A. Drummond, Ph.D. Scientific Director
FROM OUR LEADERSHIP
Hermann
Haller, M.D. President
Iain A. Drummond, Ph.D. Scientific Director
FROM OUR LEADERSHIP
Hermann

JAROD ROLLINS, PH.D. ASSISTANT PROFESSOR
JAROD ROLLINS, PH.D. ASSISTANT PROFESSOR












